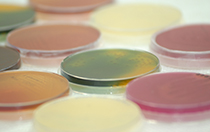
Human Genetics

Research conducted in human population and diversity, genetic diseases and genetic association studies.

Research activities in tropical and emerging infectious diseases such as malaria, dengue and hepatitis.


Research conducted in human population and diversity, genetic diseases and genetic association studies.
Research activities in tropical and emerging infectious diseases such as malaria, dengue and hepatitis.
